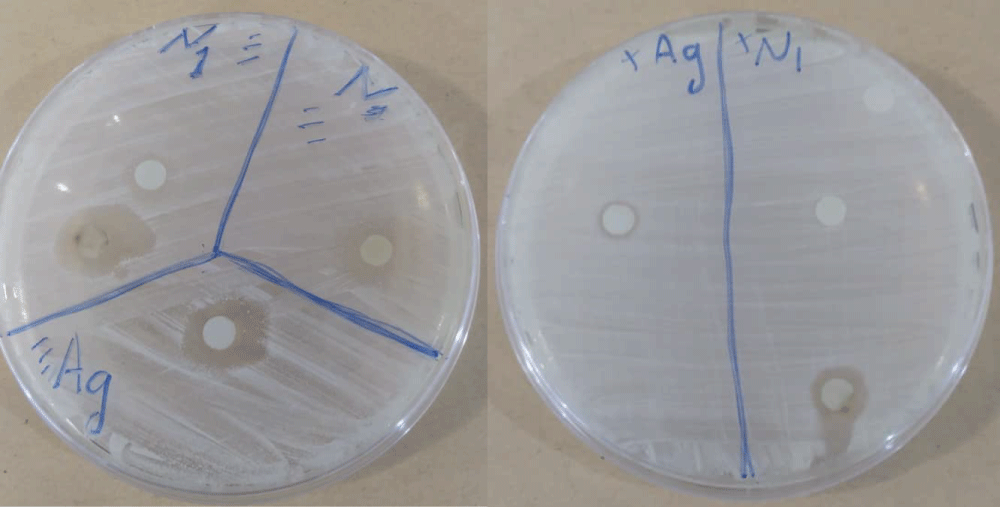

Green Synthesis of Silver Nanoparticles and Silver Nanowires of Mentha Piperita Leaf Extract and Evaluation of their Antibacterial Activity
Abstract
The utilization of plant extracts for synthesizing silver nanoparticles has gained significant traction in the field of medicine. In the current study, the synthesis of silver nanoparticles using Mentha piperita leaf extract in an aqueous solution was prepared. Following this, silver nanoparticles were synthesized utilizing the Mentha piperita leaf extract in conjunction with a 1 mM silver nitrate solution. Scanning electron microscopy (SEM) analysis revealed two types of molecules (silver nanoparticles and silver nanowires). The size of the silver nanoparticles was ranging from 42 nm to 50 nm. Whereas silver nanowires sizes were ranged from 36 nm to 110 nm. EDX study appeared the optical absorption peak was detected at 3 keV, which is the characteristic peak for the absorbed metallic silver nanoparticles. FTIR analysis identified the possible functional group involved in the reduction of Ag (1) metal ions into Ag (0) nanoparticles. In addition, the antibacterial activity of synthesized silver nanoparticles was also examined and the results showed good antibacterial activities against E. coli and Streptococcus aureus bacteria.
Keywords
Green synthesis, Menta piperita leaf extract, Sliver nanoparticles and silver nanowires, antibacterial activity
Introduction
Nanoparticles (NPs) are materials that exhibit unique physical and chemical properties due to their nanoscale size, typically ranging from 1 to 100 nanometers. Nanoparticles (NPs) have many properties such as high surface-to-volume ratios, enhanced reactivity, distinctive optical, and magnetic...etc. Making the (NPs) highly applicable in fields such as medicine, electronics, and environmental sciences [1,2]. The synthesis of nanoparticles has been traditionally achieved through physical and chemical methods such as citric acid, or sulfite etc. However, these approaches often involve toxic chemicals, high energy consumption, and environmental pollution. As a result, the scientific community has increasingly turned to green synthesis methods, which employ natural sources such as plant extracts, bacteria, and fungi to reduce the environmental impact and make the process more sustainable [3]. The use of plant extracts in nanoparticle synthesis has gained significant attention due to the presence of various phytochemicals that can act as reducing agents, stabilizers, and capping agents [4]. Among plants, Mentha spp. (mint) has emerged as a promising candidate for green synthesis due to its rich phytochemical composition, which includes flavonoids, phenolic compounds, and terpenoids [5]. Mint leaf extract is particularly effective in the reduction of metal ions, transforming them into nanoparticles while also providing stabilization and preventing aggregation of the produced nanoparticle [6,7]. The synthesis of nanoparticles using mint leaf extract typically involves the reduction of metal salts, such as silver nitrate (AgNO 3 ), gold chloride (AuCl 3 ), or copper sulfate (CuSO 4 ), by the bioactive compounds present in the mint extract [8]. This reduction is often more efficient and environmentally friendly than conventional chemical methods and stability in aqueous solution [9]. Recently, it was found that synthesized silver nanoparticles using Mentha piperita leaf extract resulted in spherical particles. Silver nanoparticles have diverse in vitro and in vivo applications [10]. This synthesis method is more convenient for pharmaceutical and biomedical applications. In the present study an attempt has been made for the synthesis of silver nanoparticles by reducing the silver ions present in the solution of silver nitrate with aqueous leaf extract of Mentha piperita . Also, in this study by using the green synthesis of silver nanoparticles using Mentha piperita leaves extract explore the synthesis of silver nanoparticles and silver nano wires. Further these synthesized nanoparticles were tested against different antibacterial activity.
Materials and Methods
Material
Silver nitrate was purchased from BDH Chemicals Ltd., and double-distilled deionized water was utilized in the experiment. Mentha piperita plant was collected from the north of Al-Khums city, Libya region (32°51'45" N and 14°15'39" E) in 2022. The studied plant was identified by a specialist taxonomist from Botany department, Faculty of Science, El Mergib University. The plant leaves were meticulously cleaned and washed with distilled water to eliminate any residual dust particles. Subsequently, the leaves were air-dried in the shade for approximately 8-10 days. Following this, they were subjected to an oven at 40°C for 3 hours before being finely ground into powder using a grinder.
Preparation of leaf extract
For the leaf extract solution preparation, 5 g of fine powder was placed in a 250 ml conical flask and combined with 100 ml of distilled water. The mixture was then boiled at 100°C for 10 minutes. Subsequently, the leaf extract was filtered and collected in a separate conical flask using Whatman filter paper.
Synthesis of silver nanoparticles : 1 mM AgNO 3 solution was meticulously prepared and stored in an amber-colored bottle. Subsequently, 50 ml of this solution was transferred into a flask containing a magnetic bead, which was then placed on a magnetic stirrer. Following this, 5 mL of leaf extract was slowly added drop by drop to the AgNO 3 solution with gentle heating at 50-60°C. The color transformation from yellow to dark brown signified the successful formation of silver nanoparticles. The conical flask was then left to incubate at room temperature for 48 hours before being subjected to centrifugation at 6,000 rpm for 15 minutes.
Characterization techniques : The characterization of the silver nanoparticles included Ultraviolet-visible Spectroscopy (UV-Vis) analysis conducted using a HACH LANGE- DR-3900 instrument. The size, morphology, and composition of the nanoparticles were examined through scanning electron microscopy (SEM), energy dispersive X-ray (EDX) analysis using JEO. Additionally, the functional groups of the silver nanoparticles were identified utilizing FT-IR analysis performed on a Perkin Elmer FT-IR Spectrometer Frontier.
Anti-bacterial activity : The research investigated the antibacterial efficacy of silver nanoparticles against two bacterial strains, E.coli (Negative-Gram) and Streptococcus aureus (Positive-Gram). The disk diffusion method was employed to assess the antibacterial properties of the silver nanoparticles. The respective bacteria strains were evenly spread on Petri dishes, following which disks soaked in distilled water (control), Ag NO 3 solution, and silver nanoparticles (100 µg/ml) were placed on the dishes. The Petri dishes were then incubated at 37°C. After 24 hours, the zone of inhibition around each disk was measured using a ruler to evaluate the antibacterial activity.
Results and Discussion
Synthesis of silver nanoparticles
The silver nanoparticles were synthesized utilizing Mentha piperita leaf extract following the methodology outlined by Linga Rao and colleagues [11]. The formation of silver nanoparticles was evidenced by a color transition from yellowish to dark brown upon the addition of Mentha piperita leaf extract to the silver nitrate solution, as depicted in figure 1. This alteration in color is attributed to the conversion of ionic silver to metallic silver, as elucidated by Hussain and his team [10].
Characterization of silver nanoparticles
UV-Vis Spectroscopy : The formation of the synthesized silver nanoparticle was achieved through UV-visible spectrum analysis, revealing a prominent absorbance peak at 464 nm, as illustrated in figure 2. This finding aligns with the results reported by Gabriela and his group, who also observed a characteristic absorption band for silver nanoparticles ranged from 438-470 nm [12]. The occurrence of this peak is attributed to the specific surface plasmon resonance (SPR) excitation of the silver nanoparticles, as explained by Das and his colleagues [13]. However, the extended wavelength could also be indicative of the formation of silver nanowires of Mentha piperita leaves aqueous extract.
SEM of silver nanoparticles : The morphology and size of the silver nanoparticles (AgNPs) were examined using scanning electron microscopy (SEM), as illustrated in figure 3. The SEM images revealed the spherical shape of the AgNPs, with sizes ranging from 42 nm to 50 nm. These findings are consistent with the research of Rani who found the size of silver nanoparticles of Mentha piperita leave extract 50 nm [14]. Furthermore, The SEM images unexpectedly revealed the presence of silver nanowires with diameters ranged from 36 nm to 110 nm, aligning with the work of Kaya and kilic, who observed the formation of silver nanowires from Lavandula officinalis using a centrifuge purification [15].
EDX analysis of silver nanoparticles : The EDX analysis exhibited a robust signal in the silver region, providing confirmation of the presence of silver nanoparticles, as depicted in figure 4. The optical absorption peak was noted at 3 keV, a characteristic absorption value for metallic silver nanoparticles attributed to surface plasmon resonance [16]. Furthermore, additional peaks corresponding to Cl, O, Mg, K and C, were observed. These peaks may be attributed to the biomolecules or chemical components present in the Mentha piperita leaf extract that are commonly associated with the surface of the AgNPs [17].
IR of silver nanoparticles : FTIR spectroscopy was conducted to analyse the biosynthesized silver nanoparticles using Mentha piperita leaf extract. A comparison was made between the IR spectra of the Mentha piperita leaf extract and the biosynthesized silver nanoparticles. The IR spectrum of the Mentha piperita leaf extract exhibited absorption bands within the range of 3307.81 cm -1 and 787.31 cm -1 , as depicted in figure 5. On the other hand, the AgNPs derived from the Mentha extract displayed absorption bands ranging from 3323.98 cm -1 to 814.08 cm -1 , as illustrated in figure 5. The wide band observed at 3307.81 cm -1 in the Mentha leaf extract shifted to 3323.98 cm -1 , has suggested that this particular absorption band is associated with the presence of OH groups found in alcohols and phenolic compounds [18]. The vibrational band at 2923.54 cm -1 shifted to 2940.23 cm -1 , indicating the stretching vibration of C-H aliphatic compounds. Moreover, the distinct peak at 2848.22 cm -1 in the Mentha extract corresponds to the C=C stretching mode, which diminishes in intensity upon the formation of AgNPs at 2855.21 cm -1 . In the original extract, the absorption band of C=O is observed at 1732.86 cm -1 , signifying the presence of carbonyl-containing compounds. However, in the AgNPs, this band disappears, suggesting the involvement of C=O compounds in the bio-reduction of silver ions [19]. The peaks at 1603.01 cm -1 and 1410.99 cm -1 are primarily attributed to the aromatic C=C and C-N stretching vibrations of amine functional groups, as indicated by Yan-Yu, et al. in 2016. In the AgNPs, a new band emerges at 1365.32 cm -1 , potentially linked to the N-O symmetry stretching of a nitro compound, as suggested by Mandal, et al. [20] Similarly, the sharps peaks at 1247.83 cm -1 and 1008.91 cm -1 in the original extract are associated with the C-O and C-H stretching. These bands in AgNPs were changed into 1277.86 cm -1 and 1048.98 cm -1 . The bands observed at 806.31 cm -1 and 814.08 cm -1 indicate the presence of C-H bonds in aromatic compounds within both the Mentha piperita extract and the biosynthesized AgNPs. The infrared spectra result of the produced AgNPs reveal the existence of characteristic functional groups like alcohols, phenols, aldehydes, flavonoids, and amines. These groups are likely responsible for the bioreduction and stabilization of the synthesized silver nanoparticles [21].
Anti-bacterial activity
The study investigated the antibacterial properties of silver nanoparticles synthesized from Mentha piperita leaf extract. The synthesised silver nanoparticles were tested for their antibacterial efficacy against two types of bacteria: E. coli (Gram-negative) and Streptococcus aureus (Gram-positive) using the disc diffusion method for antibacterial susceptibility testing [22]. A comparison was made between the AgNPs from Mentha piperita leaf extract (N1) and AgNO 3 (Ag) as depicted in figure 6.
The results demonstrated that the disc diffusion method confirmed the antibacterial effectiveness of the AgNPs. The inhibition zones exhibited a maximum diameter of 10 mm (N1) against E. coli and 8 mm (N1) against Streptococcus aureus, as shown in table 1. The study highlighted that the AgNPs from Mentha piperita leaf extract (N1) exhibited good antibacterial activity against both types of bacteria. Similar findings were reported by Gabriela, et al. regarding the antibacterial activity of AgNPs against E. coli and Streptococcus aureus [12]. It was noted that the size of the silver nanoparticles influenced the extent of inhibition [23].
Conclusion
In summary, the green synthesis of silver nanoparticles using Mentha piperita leaf extract was successfully performed. The formation of these nanoparticles was characterized using several analytical techniques, UV-Vis Spectroscopy, SEM, EDX, FTIR. Additionally, the synthesized silver nanoparticles exhibited good antibacterial activity, indicating their potential as an effective antibacterial agent for future applications in medicine. Furthermore, the presence of silver nanowires Mentha piperita leaf extract suggests promising applications in future electronic devices.
References
- Christian P, Von der Kammer F, Baalousha M, et al. (2008) Nanoparticles: Structure, properties, preparation and behaviour in environmental media. Ecotoxicology 17: 326-343.
- Beyth N, Houri-Haddad Y, Domb A, et al. (2015) Alternative antimicrobial approach: Nano-antimicrobial materials. Evid Based Complement Alternat Med 2015.
- Iravani S (2011) Green synthesis of metal nanoparticles using plants. Green Chemistry 13: 2638-2650.
- Makarov VV, Love AJ, Sinitsyna OV, et al. (2014). "Green" nanotechnologies: Synthesis of metal nanoparticles using plants. Acta naturae 6: 35-44.
- Hosein FM, Roodabeh B, Ali G, et al. (2017) Pharmacological activity of Mentha longifolia and its phytoconstituents. J Tradit Chin Med 37: 710-720.
- Hejna M, Kovanda L, Rossi L, et al. (2021) Mint oils: In vitro ability to perform anti-inflammatory, antioxidant, and antimicrobial activities and to enhance intestinal barrier integrity. Antioxidants 10: 1004.
- Adeyemi JO, Oriola AO, Onwudiwe DC, et al. (2022) Plant extracts mediated metal-based nanoparticles: Synthesis and biological applications. Biomolecules 12: 627.
- Rai MK, Deshmukh SD, Ingle AP, et al. (2012) Silver nanoparticles: The powerful nanoweapon against multidrug-resistant bacteria. J Appl Microbiol 112: 841-852.
- Sharma P, Saxena R, Sharma A (2020) Plant-mediated synthesis of silver nanoparticles: Mechanisms and applications. Environmental Toxicology and Pharmacology 74: 103307.
- Hussain Z, Jahangeer M, Sarwar A, et al. (2023) Synthesis and characterization of silver nanoparticles mediated by the Mentha piperita leaves extracts and exploration of its antimicrobial activities. J Chil Chem Soc 68.
- Rao ML, Savithramma N (2011) Biological synthesis of silver nanoparticles using svensonia hyderabadensis leaf extract and evaluation of their antimicrobial efficacy. Biology, Chemistry, Environmental Science, Materials Science, Medicine.
- Gabriela ÁM, Gabriela MDOV, Luis AM, et al. (2017) Biosynthesis of silver nanoparticles using mint leaf extract ( Mentha piperita ) and their antibacterial activity. Advanced Science, Engineering and Medicine 9: 914-923.
- Das VL, Thomas R, Varghese RT, et al. (2014) Extracellular synthesis of silver nanoparticles by the Bacillus strain CS 11 isolated from industrialized area. 3 Biotech 4: 121-126.
- Rani B (2019) Biosynthesis of silver nanoparticles from aqueous leaf extract of Mentha Piperita and its antimicrobial activity against intestinal pathogens. International Journal of Innovative Science and Research Technology 4: 308-313.
- Kaya H, Kilic S (2022) Relationship of photocatalysis with flavonoids in silver nanowire synthesis with herbal extract ( Lavandula officnalis L). Süleyman Demirel Üniversitesi Fen Bilimleri Enstitu?su? Dergisi 26: 275-284.
- Magudapathy P, Gangopadhyay P, Panigrahi BK, et al. (2001) Electrical transport studies of Ag nanoclusters embedded in glass matrix. Physica B-condensed Matter 299: 142-146.
- Banerjee P, Satapathy M, Mukhopahayay A, et al. (2014) Leaf extract mediated green synthesis of silver nanoparticles from widely available Indian plants: Synthesis, characterization, antimicrobial property and toxicity analysis. Bioresources and Bioprocessing 1.
- Najeh H, Abbas MB, Amal J (2019) Biosynthesis of silver nanoparticles by Mentha spicata ethanolic leaves extract and investigation the antibacterial activity. AIP Conference Proceedings 2144.
- Sadeghi B, Gholamhoseinpoor F (2015) A study on the stability and green synthesis of silver nanoparticles using Ziziphora tenuior (Zt) extract at room temperature. Spectrochim Acta A Mol Biomol Spectrosc 134: 310-315.
- Mandal S, Phadtare S, Sastry M (2005) Interfacing biology with nanoparticles. Current Applied Physics 5: 118-127.
- Thatyana M, Dube NP, Kemboi D, et al. (2023) Advances in phytonanotechnology: A plant-mediated green synthesis of metal nanoparticles using Phyllanthus plant extracts and their antimicrobial and anticancer applications. Nanomaterials 13: 2616.
- Hussein EAM, Mohammad AAH, Harraz FA, et al. (2019) Biologically synthesized silver nanoparticles for enhancing tetracycline activity against Staphylococcus aureus and Klebsiella pneumoniae . Braz Arch Biol Technol 62.
- Murugan N, Natarajan D (2018) Bionanomedicine for antimicrobial therapy - A case study from Glycosmis pentaphylla plant mediated silver nanoparticles for control of multidrug resistant bacteria. Letters in Applied NanoBioScience 8: 523-540.
Corresponding Author
Samira Hribesh, Department of Chemistry, Faculty of Science, Al-Mergib University /Al-Khums, Libya.
Copyright
© 2025 Sasi M, et al. This is an open-access article distributed under the terms of the Creative Commons Attribution License, which permits unrestricted use, distribution, and reproduction in any medium, provided the original author and source are credited.